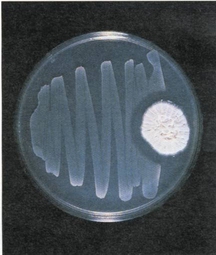
頭孢唑南

概述
 頭孢唑南
頭孢唑南別名:頭孢唑喃鈉、頭孢唑南鈉、頭孢唑喃鈉、CefuzonamSodium、CZON、Cosmosin
英文名稱:Cefuzonam
粉針劑:每支0.25g、0.5g、1g。
性狀:抗菌譜與其他第三代頭孢菌素類似,對多種β內醯胺酶穩定,對革蘭陽性菌、革蘭陰性需氧菌、厭氧菌等均有較好療效。耐甲氧西林鈉的金葡菌及其他某些耐第三代頭孢菌素的細菌亦對本品敏感。對大腸桿菌、克雷白菌、變形桿菌、流感桿菌等具有強大的殺菌作用,對葡萄球菌、鏈球菌有良好的抗菌力。
作用機制:頭孢唑喃作用機制與其它頭孢菌素類藥相似。頭孢唑南對β-內醯胺酶穩定,對青黴素結合蛋白(PBP)1a、1b、3有高度親和力,通過抑制肽多糖形成交聯,抑制細菌細胞壁的合成而達殺菌作用。對於耐甲氧西林、頭孢烯的金黃色葡萄球菌,因對其出現的特異性青黴素結合蛋白(PBP)2也具有親和性,故也顯示出抗菌活性。
抗菌譜:頭孢唑喃鈉對葡萄球菌屬、鏈球菌屬及對甲氧西林、頭孢烯耐藥的金色葡萄球菌等革蘭陽性菌,腸桿菌屬、沙雷菌屬、擬桿菌屬等革蘭陰性菌均有較強的抗菌作用。
藥動學:頭孢唑喃鈉靜脈給藥後,吸收良好,藥物吸收後可向膽汁及膽囊組織移行,也可向痰液、子宮、卵巢、骨盆死腔滲出液、骨髓、腦脊髓液等移行,少向乳汁移行。本品主要經腎隨尿液排泄。
作用與用途
本品為第四代半合成頭孢菌素,具廣譜抗菌活性,對大腸桿菌、變形桿菌屬、克雷白菌屬及流感桿菌具強抗菌力。抗菌譜與其他第三代頭孢菌素類似,對多種β內醯胺酶穩定,對革蘭陽性菌、革蘭陰性需氧菌、厭氧菌等均有較好療效。耐甲氧西林鈉的金葡菌及其他某些耐第三代頭孢菌素的細菌亦對本品敏感,對葡萄球菌、鏈球菌有良好的抗菌力。
臨床主要用於呼吸系統及泌尿系統感染如支氣管炎、扁桃體炎、腎盂腎炎、尿路感染、腹膜炎、膽囊炎、膽管炎、肝膿腫、腦膜炎及婦科感染等。
本品組織分布良好,主要以原形經腎臟排出,半衰期約為1.1h。
適應症
頭孢唑喃鈉可用於敏感菌引起的下列感染:
1.敗血症。
2.呼吸道感染。
3.肝膽感染。
4.腹膜炎。
5.腦膜炎。
6.骨髓炎、關節炎等。
7.子宮旁結締組織炎。
8.肛周膿腫以及外傷、手術創口的繼發感染。
注意事項
青黴素
青黴素物和速尿等利尿藥並用可增強腎臟毒性,合用時應慎重。
1.交叉過敏:頭孢唑南與其它頭孢菌素類藥有交叉過敏,與青黴素類藥有部份交叉過敏,禁用於對本品有休克史的病人。
2.禁忌症:(1)對頭孢唑南過敏者禁用。(2)對其它頭孢菌素類藥物過敏的患者禁用。
3.慎用:於對頭孢烯類、青黴素類有過敏史的病人,本人或雙親、弟兄有易發生支氣管哮喘、皮疹、蕁麻疹等變態反應的體質的病人,腎功能嚴重不全的病人,肝功能嚴重不全的病人,口服吸收不良的病人及不經口營養的病人,老年病人,全身狀態嚴重虛弱的病人(有時出現維生素K缺乏症)。(1)對青黴素類抗生素藥過敏的患者慎用。(2)因頭孢唑南對孕婦及嬰兒的用藥安全性未確定,故孕婦及早產兒、新生兒應慎用。(3)對肝、腎功能不全者慎用。(4)高度過敏性體質者慎用。(5)高齡體弱患者以及全身狀況差者慎用。
4.對診斷的影響:少數患者用藥後可出現鹼性磷酸酶、血清丙氨酸氨基轉移酶、血清門冬氨酸氨基轉移酶升高;血清肌酐和血尿素氮升高;嗜酸粒細胞增多,白細胞、血小板減少等。
5.長期用藥時應常規監測肝、腎功能和血象。
6.對臨床檢查的影響:以本尼迪特試劑、菲林試劑及Clinitest法檢查尿糖時,有時會出現陽性。下接庫姆斯試驗有時出現陽性。
7.使用上的注意事項:本品僅供靜注。靜脈內大量給藥時罕見血管痛和血栓性靜脈炎,為預防此類情況,應注意注射液的配製、注射部位及注射方法。注射速度應儘可能慢。溶解後應即使用,不得已時應在24h內使用。
8.其他:使用本品應定期檢查肝功能、腎功能和血象。貯存:室溫保存,有效期2年。
不良反應
 頭孢唑南合成線路圖
頭孢唑南合成線路圖2.少數患者用藥後可出現噁心、嘔吐、食慾下降、腹痛、腹瀉、便秘等消化道症狀。
3.少數患者用藥後可出現一過性肝酶升高,腎功能異常。腎臟:偶見BUN上升、血中肌酐上升、蛋白尿、少尿等,出現時應中止給藥。
4.有報導大劑量、長時間用藥可致凝血功能障礙(血小板減少、凝血酶原時間延長、凝血酶原活力降低等)。
5.少數患者長期用藥後可導致耐藥菌的大量繁殖,引起菌群失調、二重感染。還可能引起維生素K、維生素B缺乏。
6.靜脈注射時,如劑量過大或速度過快可產生注射部位灼熱感、血管疼痛,嚴重者可出現血栓性靜脈炎。血液:偶見粒細胞減少、嗜酸粒細胞增多,罕見血小板減少、紅細胞減少。其他頭孢烯類可引起溶血性貧血。
7.過敏:皮疹、蕁麻疹、紅斑、瘙癢、丘疹、發熱、淋巴結腫脹等,出現時應中止給藥。
8.肝臟:偶見SGOT、SGPT、ALP上升,罕見膽紅素上升。
9.胃腸道:罕見伴發熱、腹痛、白細胞增多、粘液血便以急性腹瀉為主要症狀的假膜性大腸炎,
藥物相互作用
本品作用機制為抑制細胞壁的合成。本品對β-內醯胺酶穩定。對青黴素結合蛋白(PBP)Ia,Ⅱb及Ⅲ有高度親和力,抑制肽多糖形成交聯,而顯示殺菌作用。對於耐甲氧西林、頭孢烯的金黃色葡萄球菌,因對其出現的特異性青黴素結合蛋白2也具親和性,故也顯示抗菌活力。毒理:LD50(mg/kg)小鼠靜注雄性≥4800,雌性4117。無致畸形,對生殖能力也無作用。
1.頭孢唑喃鈉與氨基糖苷類抗生素類藥合用可增加腎毒性。
2.頭孢唑喃鈉與呋塞米、速尿等強利尿劑合用可增加腎毒性。
給藥說明
1.頭孢唑南鈉與氨基糖苷類藥為配伍禁忌,因此兩類藥物聯合套用時,不能置於同一容器內。
2.頭孢唑南鈉僅供靜脈給藥,且給藥時速度宜慢。
用法與用量
成人:靜脈注射:成人每日1-2g,分2次,重症可增至4g,分2-4次,緩慢靜脈注射。
靜脈滴註:成人每日1-2g,分2次,重症可增至4g,分2-4次。靜滴時,每次加入100mL溶液中滴注1小時。
兒童:靜脈注射:兒童40-80mg/(kg·d),重症可增至200mg/(kg·d),每日分3-4次,緩慢靜脈注射。
靜脈滴註:兒童40-80mg/(kg·d),重症可增至200mg/(kg·d),每日分3-4次。靜滴時,每次加入100mL溶液中滴注1小時。
生產廠家
鄭州南界藥業有限責任公司
台州市新星醫藥化工有限公司
上海匯瑞生物科技有限公司等
頭孢唑肟原料藥生產廠家
上海希地醫藥科技有限公司
上海齊奧化工有限公司
重慶浩康醫藥化工有限公司
河北九派實業集團

